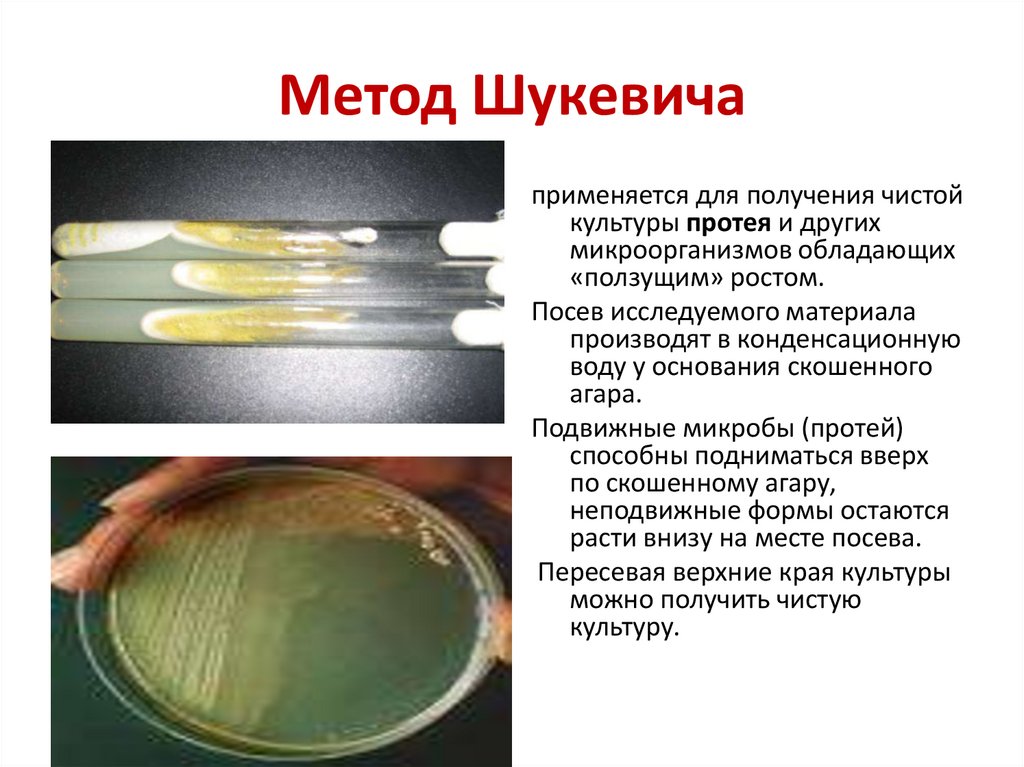
Метод Шукевича

Similar presentations:
Чистые культуры микроорганизмов. Определение их свойств, типирование
1. Чистые культуры микроорганизмов. Определение их свойств, типирование. Методы определения чувствительности микроорганизмов к
антибиотикам2. ОПРЕДЕЛЕНИЯ
• Чистая культура совокупность клеток, котораясодержит микроорганизмы одного вида.
• Штамм — чистая культура микроорганизмов
или культура клеток, изолированная в
определённое время и в определённом месте.
Штамм не является таксономической
категорией, один и тот же штамм не может
быть выделен второй раз из того же
источника в другое время!
• Клон - популяция клеток, полученная из одной
(родительской) клетки путем бесполого
размножения.
3. Выделение чистой культуры микроорганизмов
• позволяет изучить морфологические,• культуральные,
• биохимические,
• антигенные
• и другие признаки
по совокупности этих признаков определяется
видовая и типовая принадлежность
микроорганизма,
то есть производится его идентификация
4. Чистые культуры используются при:
• изучении систематики и изменчивостимикроорганизмов;
• диагностике для идентификации возбудителей
порчи пищевых продуктов;
• диагностике инфекционных болезней;
• в микробиологической промышленности в
качестве исходного материала для получения
ферментов, вакцин, антибиотиков, витаминов,
стероидных гормонов и других продуктов;
• в пищевой промышленности: в виноделии,
пивоварении, производстве молочнокислых
продуктов и хлеба.
5. Забор материала
• Кровь для посева следует брать до начала антибактериальнойтерапии; на высоте подъема температуры; с соблюдением
правил асептики. Посев производится в двойную и
тиогликолевую среду в соотношении 1:10.
• Моча для посева берется до начала антибактериальной
терапии. Моча здорового человека и животного стерильна. От
начала взятия пробы мочи до начала исследования в
лаборатории должно проходить не более 1-2 часов.
• Гной получают с помощью стерильного шприца или
стерильного ватного тампона.
• Испражнения на патогенные энтеробактерии берут
ректальными петлями, смоченными консервантом, и
помещают в пробирку с консервирующей средой.
6. Направление на исследование
• 1. название материала• 2. учреждение, направляющее материал
• 3. вид животного
• 4. возраст
• 5. дата заболевания
• 6. дата взятия материала
• 7. предполагаемый клинический диагноз
• 8. подпись врача, направляющего материал
7. Основы методов выделения чистых культур:
• 1. Механическое разобщениебактериальных клеток;
• 2. Действие физических и химических
факторов, оказывающих избирательное
действие;
• 3. Способность некоторых бактерий
размножаться в организме.
8. Для выделения чистых культур микроорганизмов используют различные методы
• Метод Пастера• Метод Коха («пластинчатые разводки»)
• Метод Шукевича
• Метод Дригальского
• Метод Вейнберга
• Метод Хангейта
• Выделение отдельных клеток с помощью
микроманипулятора
9.
10. Метод Шукевича
применяется для получения чистойкультуры протея и других
микроорганизмов обладающих
«ползущим» ростом.
Посев исследуемого материала
производят в конденсационную
воду у основания скошенного
агара.
Подвижные микробы (протей)
способны подниматься вверх
по скошенному агару,
неподвижные формы остаются
расти внизу на месте посева.
Пересевая верхние края культуры
можно получить чистую
культуру.
11. Метод Дригальского
• материал разводят в пробиркестерильным физиологическим
раствором или бульоном.
• Одну каплю материала вносят в
первую чашку и стерильным
стеклянным шпателем
распределяют по поверхности
среды.
• Затем этим же шпателем
делают такой же посев во
второй и третьей чашках.
• изолированные колонии,
пересевают на скошенный агар
с целью накопления чистой
культуры
12. Метод Вейнберга
• для выделения чистыхкультур облигатных
анаэробов
• Посев по
Дригальскому и
культивирование в
анаэростате
• Метод разведения в
трубках Бурри
13. Метод Хангейта для выделения строгих анаэробов
14. Выделение отдельных клеток с помощью микроманипулятора
В поле зрениямикроскопа
объекты видны с
микронной
точностью
Микроманипулятор –
прибор, позволяющий
с помощью
специальной
микропипетки или
микро-петли извлекать
одну клетку из
суспензии
В держателях
операционных штативов
закрепляют
микропипетки

biology
biology








